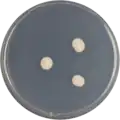
Aspergillus restrictus growing on CYA plate

Aspergillus restrictus
| Aspergillus restrictus | |
|---|---|
| Scientific classification | |
| Kingdom: | Fungi |
| Division: | Ascomycota |
| Class: | Eurotiomycetes |
| Order: | Eurotiales |
| Family: | Aspergillaceae |
| Genus: | Aspergillus |
| Species: | A. restrictus
|
| Binomial name | |
| Aspergillus restrictus | |
| Synonyms[2] | |
| |
Aspergillus restrictus is a species of fungus in the genus Aspergillus. It is from the Restricti section.[3] The species was first described in 1931.[1] It is xerophilic, frequently found in house dust. Studies have suggested that it is an allergen implicated in asthma.[4][5] In 2016, the genome of A. restrictus was sequenced as a part of the Aspergillus whole-genome sequencing project - a project dedicated to performing whole-genome sequencing of all members of the genus Aspergillus.[6] The genome assembly size was 23.26 Mbp.[6]
Growth and morphology
A. restrictus has been cultivated on both Czapek yeast extract agar (CYA) plates and Malt Extract Agar Oxoid (MEAOX) plates. The growth morphology of the colonies can be seen in the pictures below.
-
Aspergillus restrictus growing on CYA plate
Aspergillus restrictus growing on CYA plate -
 Aspergillus restrictus growing on MEAOX plate
Aspergillus restrictus growing on MEAOX plate
References
- ^ a b Smith, G. 1931, J. Textile Res. Inst. 22: 115
- ^ "Aspergillus restrictus G. Sm.: 115 (1931)". Mycobank. International Mycological Association. Retrieved 2013-12-15.
- ^ Sklenár, F.; Jurjevic, Z.; Zalar, P.; Frisvad, J.C.; Visagie, C.M.; Kolarik, M.; Houbraken, J.; Chen, A.J.; Yilmaz, N.; Seifert, K.A.; Coton, M.; Déniel, F.; Grunde-Cimerman, N.; Samson, R.A.; Peterson, S.W.; Hubka, V. (2017). "Phylogeny of xerophilic aspergilli (subgenus Aspergillus) and taxonomic revision of section Restricti". Studies in Mycology. 88: 161–236. doi:10.1016/j.simyco.2017.09.002. PMC 5678892. PMID 29158611.
- ^ Itabashi T, Hosoe T, Toyasaki N, Imai T, Adachi M, Kawai K (2007). "Allergen activity of xerophilic fungus, Aspergillus restrictus". Arerugī. 56 (2): 101–8. PMID 17347596.
- ^ Abe S. (1956). "Studies on the Classification of the Penicillia". Journal of General and Applied Microbiology Tokyo. 2 (1–2): 344. doi:10.2323/jgam.2.1.
- ^ a b "Home - Aspergillus restrictus CBS 118.33 v1.0". Mycocosm.jgi.doe.gov. Retrieved 2 May 2022.